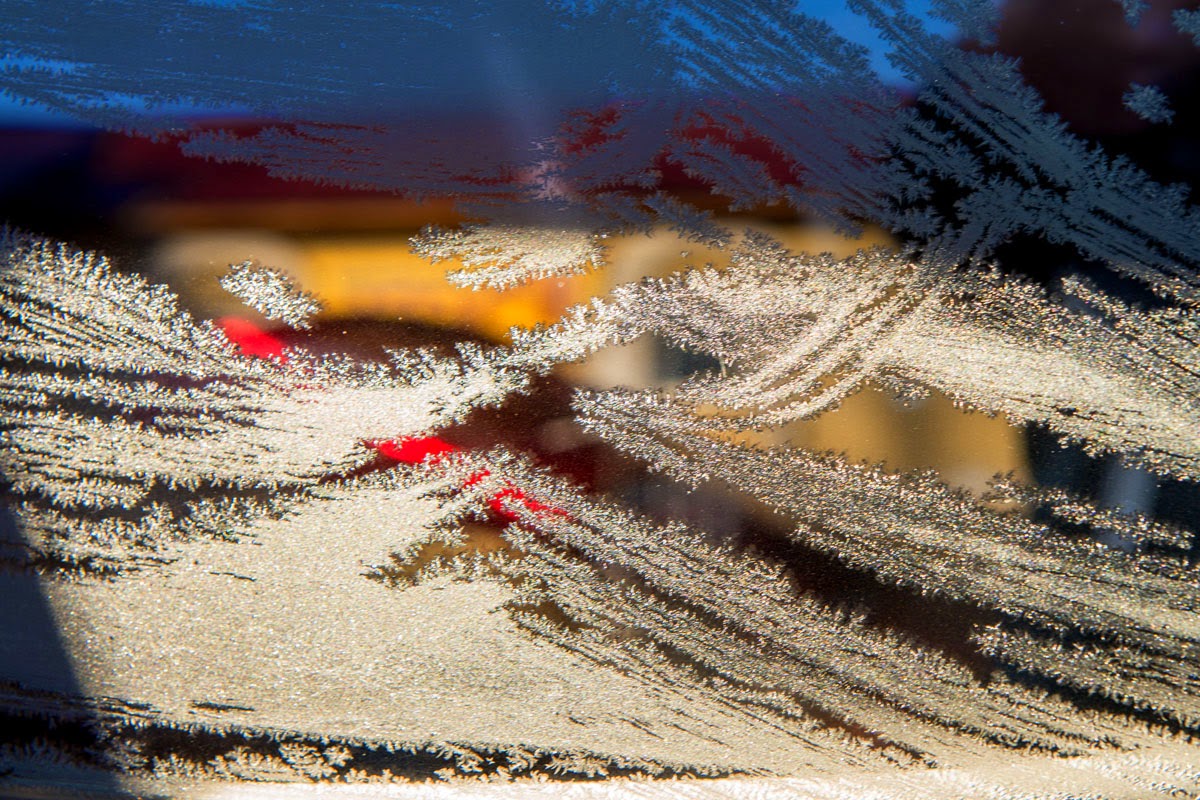

Четыре ноябрьских дня в Тверской области, по разным дорогам, городам, деревням. Чувства очень противоречивые, красивая природа, большое количество заброшенных деревень, разрушенных храмов. Районы заросшие борщевиком так, что и домов не видно. Бездорожье всюду. Кашин, Торжок, Бежецк, Весьегонск. Асфальта мало, больше грунтовые дороги. Из-за особенности грунта в этой местности почва сильно переувлажнена,вода испаряется медленно, образует водную подушку вперемешку с дорожной грязью. В планах не города, а разрушенные храмы и усадьбы.
Любимый Калязин, известная колокольня Никольского собора.
Льда еще нет, местные катают туристов до колокольни. Холодно. На минуту выглянуло солнце, чем порадовало.
Кашин.
Один из древнейших городов Тверской земли, 1287 года. В центре города речка Кашинка делает петлю в форме сердца. Главная дорога вас приведет в центр города на площадь, с памятником Ленину и старинными торговыми рядами. От сюда же дорога к центральному собору города - Воскресенский, с высокой колокольней и точнейшими часам, здесь открыта смотровая площадка на колокольне. День короткий в ноябре, а путь впереди еще длинный. Ограничились прогулкой по торговым рядам и смотровой Воскресенского собора.Колокольня высотой более семидесяти метров главенствует в композиции собора и видна практически отовсюду. Подобно своей деревянной предшественнице, колокольня служит и городской башней-часозвоней. На ней установлены куранты с датировкой на циферблатах «1872». Часовой механизм был приобретен Н. В. Терликовым на ярмарке в Лейпциге, и за это время часы ни разу не ломались.
В Кашине до 20 старинных церквей. Немногие из них сохранились полностью
Всего 100 лет назад здесь, в самом центре Кашина, на расстоянии 100 метров друг от друга стояли два уникальных собора: Воскресенский и Успенский. Про разрушенный Успенский собор в городе сейчас не вспоминают, а Воскресенскому собору повезло. Он сохранился исключительно благодаря своим размерам. Собор был самым большим зданием города, что послужило создать в нем Дом Культуры. Сейчас собор, возвращенный епархии, находится не в лучшем состоянии, но постепенно реставрируется.
К тому же это город-курорт В центре города, у источника лечебной и столовой минеральной воды, в конце XIX вв открыт санаторий. Прикупив в магазине кашинской минералки едем в дальше.
с.Алабузино.
Две церкви рядом Троицы Живоначальной 1765-1781 г.г и Церковь Смоленской иконы Божией Матери. Ранее здесь был большой комплекс и даже была открыта церковно-приходская школа. Церковь Смоленской Богоматери считается одним из любопытнейших культовых памятников классицизма, близкий постройкам арх-ра Н.А.Львова. Из далека похожа на господский дом.
Церковь Троицы Живоначальной возведена на месте существовавшего ранее одноименного деревянного храма. Это бесстолпный, трехсветный четверик, завершенный декоративным пятиглавием с трехъярусной колокольнеё в стиле классицизма.
Подьехали еще к одной колокольне, не опознана, как многие на нашем пути.
Название «Бежецк» происходит, вероятно, от «бежь» — беженцы, беглецы. Согласно преданию, селение Бежичи было основано беженцами из Новгорода. Население на 2011 год составляло 24 тысячи человек. Обыкновенный провинциальный городок со своей, отдельной, но уникальной историей. К концу XIX века Бежецк становится одним из крупнейших в России центров льняной торговли. Англия, Бельгия, Германия, Франция, Италия прекрасно знали бежецкий лен. Огромные денежные обороты дали толчок развитию Бежецка. Строились школы, больницы, храмы, купеческие дома и т.д. К 1917 г. в Бежецке насчитывалось около 20 церквей и часовен. Большинство из них были разрушены. Номер в гостинице “Русь” с видом на реку оказался холодным и унылым. Летом наверное здесь уютнее. Полное отсутствие дорог и вечернего освещения. С прогулкой по городу не получилось. Немного фото следующего утра.
Приморозило.
Про гостиницу писать не чего, переночевать можно, номер за двоих 2000 р, вода горячая с перебоями. В комплекс входить кафе, внутри довольно интересный интерьер с оленьими головами. Но работает с 22, как ночной клуб. От этого в гостинице бывает шумно спать.Нам н мешало.
речка Остречина
Иний
Гостиница с другого берега реки, летом думаю здесь красиво.
И городские дороги в свете утреннего солнца
Места, где сняты фото отмечаны на карте
Записи из этого путешествия тут:
1.Калязин-Кашин-Алабузино-Бежецк
2.Церковь Богоявления Господня села Еськи,
3.Краснохолмский Николаевский Антониев монастырь
Записи из этого путешествия тут:
1.Калязин-Кашин-Алабузино-Бежецк
2.Церковь Богоявления Господня села Еськи,
3.Краснохолмский Николаевский Антониев монастырь

Комментариев нет:
Отправить комментарий